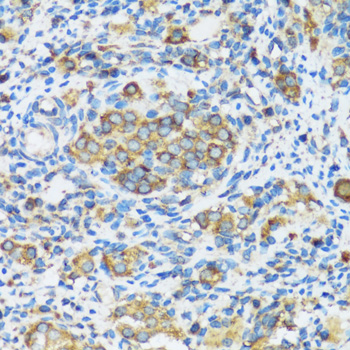
Immunohistochemistry - APOBEC3F Polyclonal Antibody
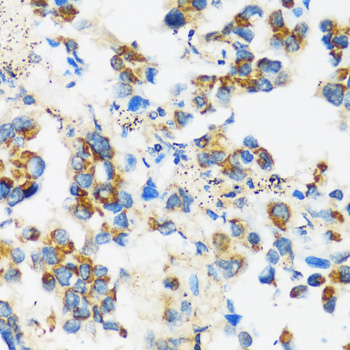
Immunohistochemistry - APOBEC3F Polyclonal Antibody
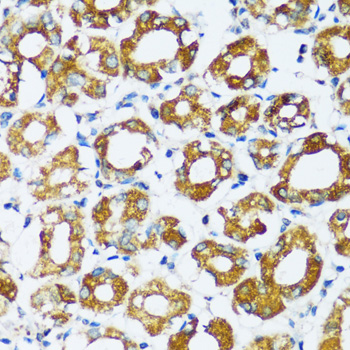
Immunohistochemistry - APOBEC3F Polyclonal Antibody
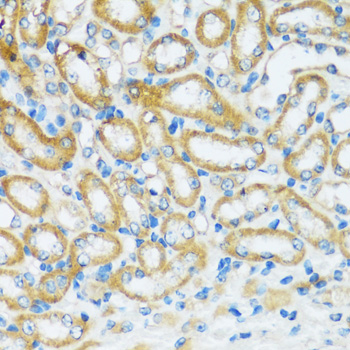
Immunohistochemistry - APOBEC3F Polyclonal Antibody

-
Product Name
APOBEC3F Polyclonal Antibody
- Documents
-
Description
Polyclonal antibody to APOBEC3F
-
Tested applications
WB, IHC
-
Species reactivity
Human, Mouse, Rat
-
Alternative names
APOBEC3F antibody; A3F antibody; ARP8 antibody; BK150C2.4.MRNA antibody; KA6 antibody; DNA dC->dU-editing enzyme APOBEC-3F antibody
-
Isotype
Rabbit IgG
-
Preparation
Antigen: Recombinant fusion protein containing a sequence corresponding to amino acids 1-65 of human APOBEC3F (NP_660341.2).
-
Clonality
Polyclonal
-
Formulation
PBS with 0.02% sodium azide, 50% glycerol, pH7.3.
-
Storage instructions
Store at -20℃. Avoid freeze / thaw cycles.
-
Applications
WB 1:500 - 1:2000
IHC 1:50 - 1:200 -
Validations
Immunohistochemistry - APOBEC3F Polyclonal Antibody
Immunohistochemistry of paraffin-embedded rat ovary using APOBEC3F antibody at dilution of 1:100 (40x lens).

Immunohistochemistry - APOBEC3F Polyclonal Antibody
Immunohistochemistry of paraffin-embedded rat heart using APOBEC3F antibody at dilution of 1:100 (40x lens).

Immunohistochemistry - APOBEC3F Polyclonal Antibody
Immunohistochemistry of paraffin-embedded human lung using APOBEC3F antibody at dilution of 1:100 (40x lens).
Immunohistochemistry - APOBEC3F Polyclonal Antibody
Immunohistochemistry of paraffin-embedded human lung cancer using APOBEC3F antibody at dilution of 1:100 (40x lens).
Immunohistochemistry - APOBEC3F Polyclonal Antibody
Immunohistochemistry of paraffin-embedded human stomach using APOBEC3F antibody at dilution of 1:100 (40x lens).

Immunohistochemistry - APOBEC3F Polyclonal Antibody
Immunohistochemistry of paraffin-embedded mouse lung using APOBEC3F antibody at dilution of 1:100 (40x lens).
Immunohistochemistry - APOBEC3F Polyclonal Antibody
Immunohistochemistry of paraffin-embedded mouse kidney using APOBEC3F antibody at dilution of 1:100 (40x lens).
-
Background
DNA deaminase (cytidine deaminase) which acts as an inhibitor of retrovirus replication and retrotransposon mobility via deaminase-dependent and -independent mechanisms. Exhibits antiviral activity against vif-deficient HIV-1. After the penetration of retroviral nucleocapsids into target cells of infection and the initiation of reverse transcription, it can induce the conversion of cytosine to uracil in the minus-sense single-strand viral DNA, leading to G-to-A hypermutations in the subsequent plus-strand viral DNA. The resultant detrimental levels of mutations in the proviral genome, along with a deamination-independent mechanism that works prior to the proviral integration, together exert efficient antiretroviral effects in infected target cells. Selectively targets single-stranded DNA and does not deaminate double-stranded DNA or single- or double-stranded RNA. Exhibits antiviral activity also against hepatitis B virus (HBV), equine infectious anemia virus (EIAV), xenotropic MuLV-related virus (XMRV) and simian foamy virus (SFV) and may inhibit the mobility of LTR and non-LTR retrotransposons. May also play a role in the epigenetic regulation of gene expression through the process of active DNA demethylation.
Related Products / Services
Please note: All products are "FOR RESEARCH USE ONLY AND ARE NOT INTENDED FOR DIAGNOSTIC OR THERAPEUTIC USE"
